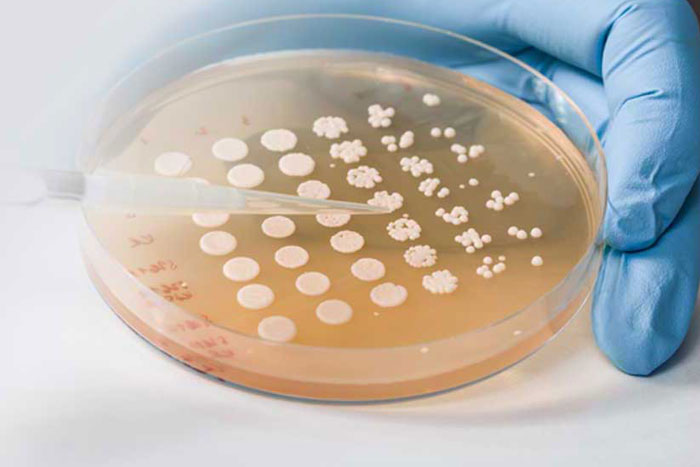

ProbioFerm specializes in probiotic fermentation, emphasizing a special focus on lactic acid bacteria. With years of experience and state of the art fermentation equipment, Probioferm is uniquely positioned to provide our customers with contract fermentation services. Our ability to scale from benchtop to small pilot runs to large scale production runs gives our customers a wide range of opportunities to introduce novel probiotic cultures to the human and animal health markets. Our manufacturing systems are designed from a priority of high purity standards and industry practices to ensure our customers a supply of high-quality cultures. Our highly trained scientists and operators work hand-in-hand with our in-house quality control laboratory to monitor crucial steps in the process ensuring the quality of our cultures and strict adherence to Good Manufacturing Practices for food and dietary supplements. Our technical expertise and attention to our customer needs uniquely positions us to offer contract fermentation services to organizations looking to expand their probiotic offerings or bring new cultures to the market.

Culture identification and starter culture stock creation

Media development and fermentation optimization

Pilot scale fermentation, separation and lyophilization

Large scale fermentation and downstream processing
To provide our customers with quality products, we maintain an in-house quality control laboratory and a highly skilled team of quality control microbiologists. Our stringent quality control system monitors for purity, strength, and identity throughout the manufacturing process.
Our quality system is modeled after the ISO 9001 standard, is cGMP compliant and meets CFR 21 Part 111 requirements. ProbioFerm is registered and audited by both the FDA and State of Iowa Department of Health. ProbioFerm is a certified Safe Feed/Safe Food facility and holds a 3rd party Good Manufacturing Practices certification.